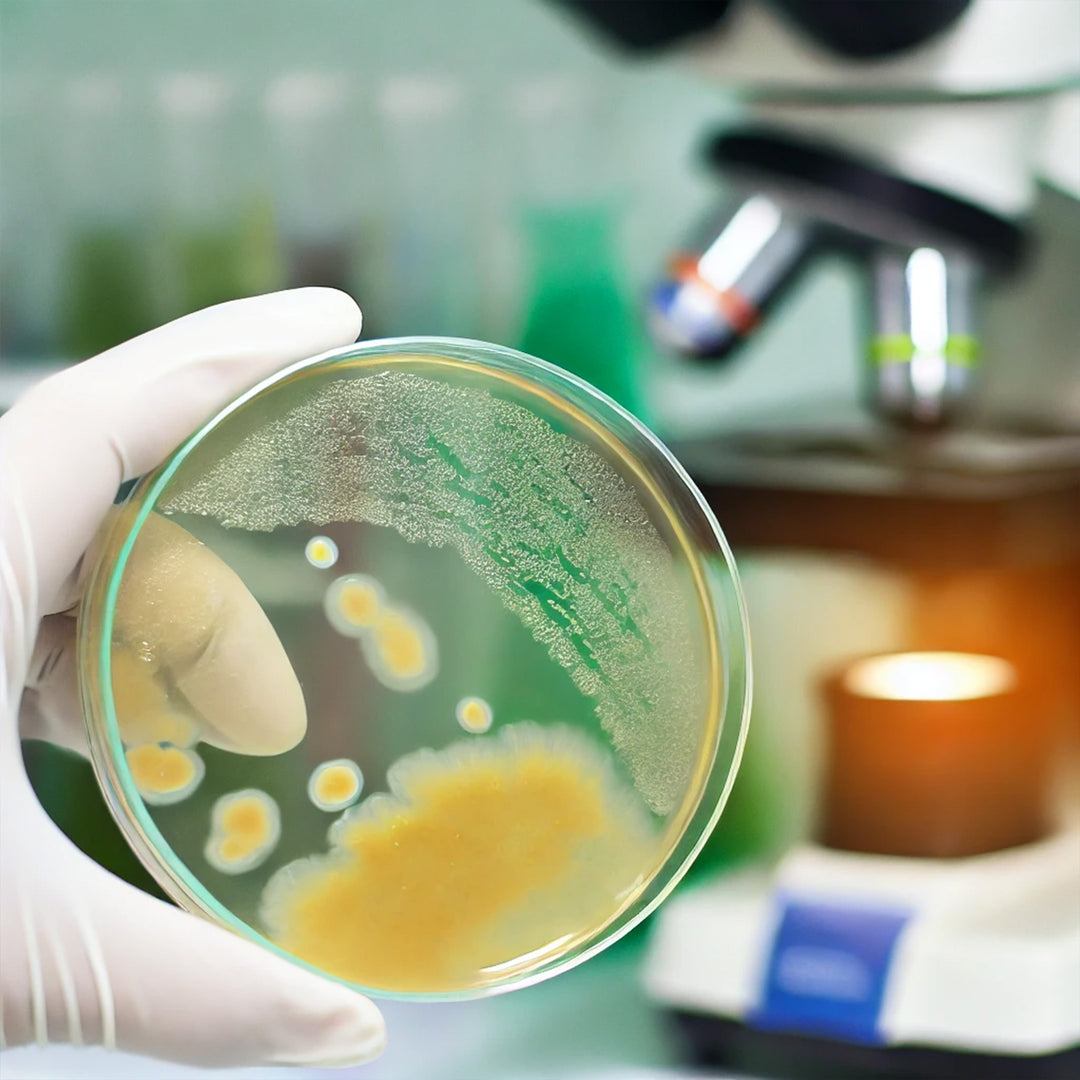

Alcohol for Makers Blog - CulinarySolvent.com

Recipe: Make Your Own Disinfectant Spray from 91% Isopropyl Alcohol (Rubbing Alcohol) When it comes to the healthy and safety of your family, friends, and coworkers, only the very best will do. While isopropyl alcohol will kill germs and viruses,...
Continue reading

Recipe: Make Your Own Disinfectant Spray from 99.9% Isopropyl Alcohol (Rubbing Alcohol) When it comes to the healthy and safety of your family, friends, and coworkers, only the very best will do. While isopropyl alcohol will kill germs and viruses,...
Continue reading
Excerpts from the infographic, source linked below: "Log” stands for logarithm, which is the exponent of 10. For example, Log-2 represents 10^2 or 10 x 10 or 100. Log Reduction stands for a 10-fold (one decimal) or 90% reduction in numbers...
Continue reading
Does Ethyl Alcohol kill germs, viruses, and bacteria? Quick Answer: Yes, if 2 conditions are met: 1.) the concentration of alcohol (ABV for either Ethanol or Isopropyl) in the solution is high enough (over 70% for most germs and viruses), AND...
Continue reading

Learn more about how to tell the type (Ethanol or Isopropyl) and strength (ABV) of your alcohol product.
Continue reading